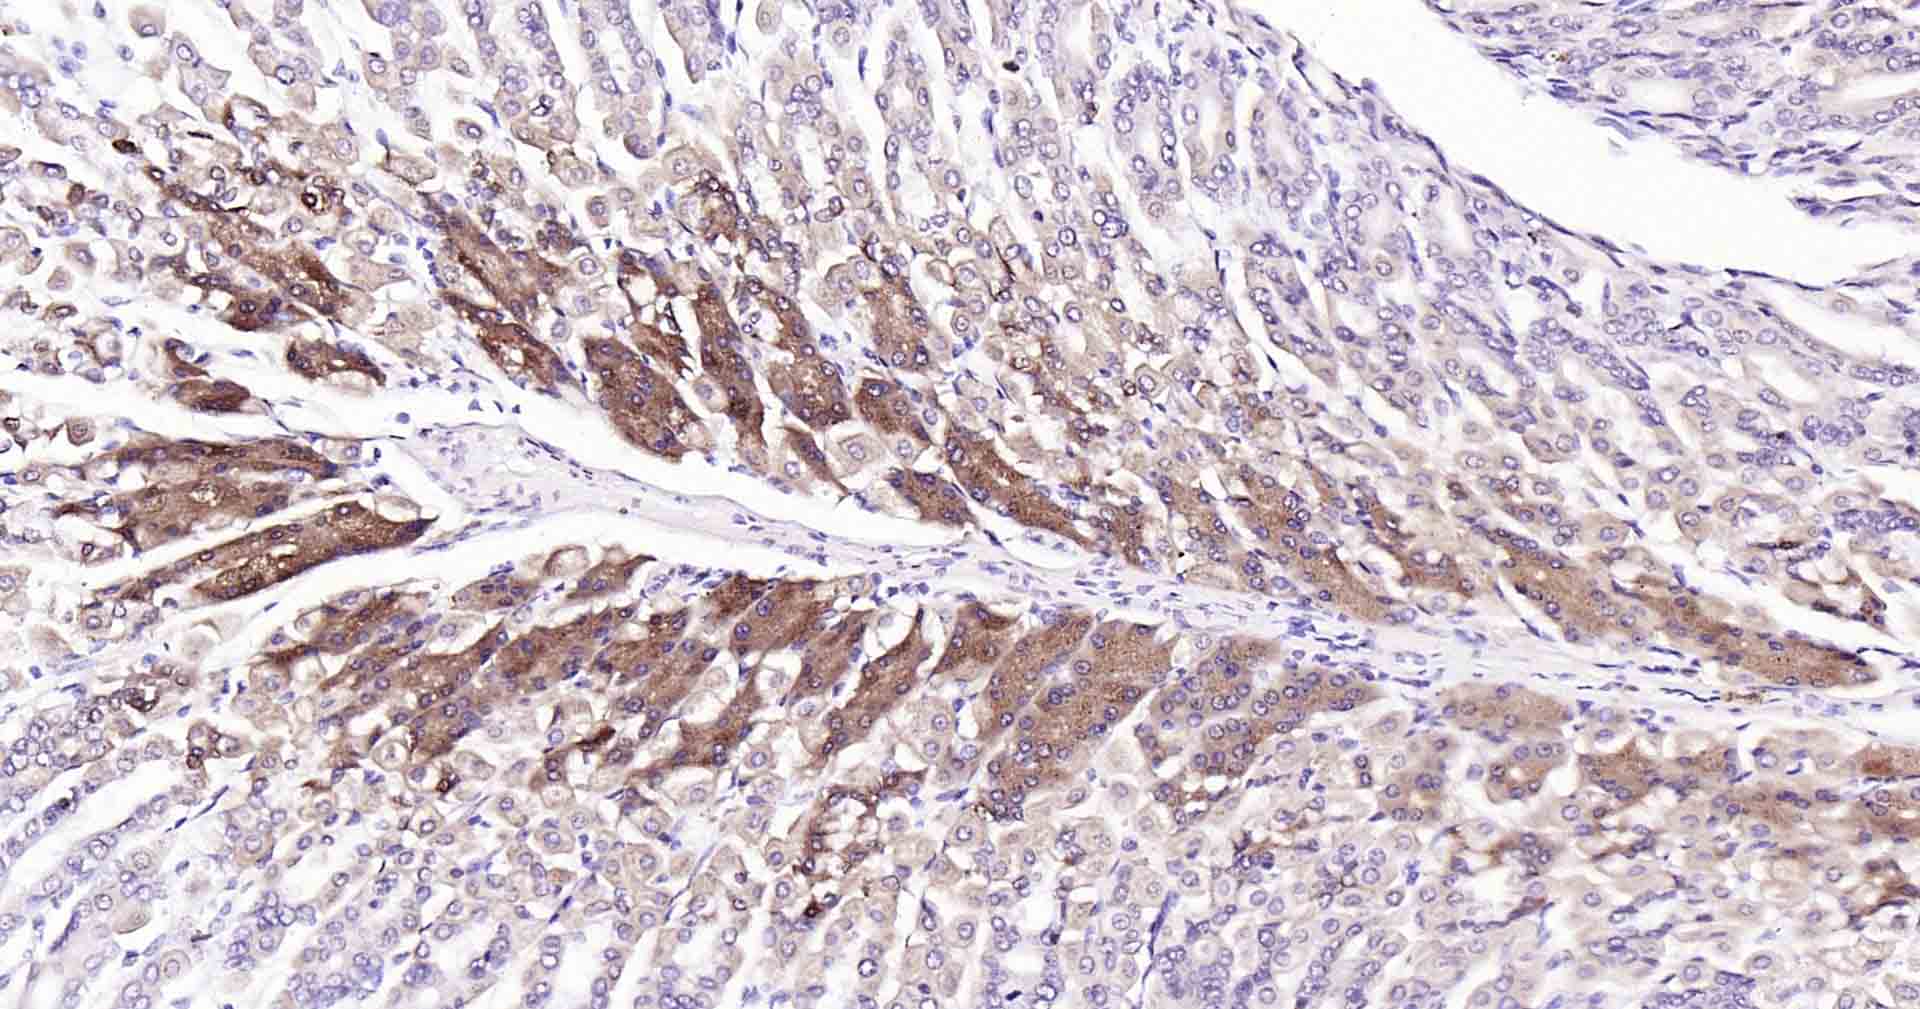
产品细节图片2

相关产品推荐更多 >
万千商家帮你免费找货
0 人在求购买到急需产品
- 详细信息
- 文献和实验
- 技术资料
- 应用范围:
产品信息以Bioss网站为准
- 规格:
50ul/100ul/25ul
| 规格: | 50ul | 产品价格: | ¥1400.0 |
|---|---|---|---|
| 规格: | 100ul | 产品价格: | ¥2500.0 |
| 规格: | 25ul | 产品价格: | ¥800.0 |
| 产品编号 | bsm-52218R |
| 英文名称 | PI3-kinase p110 subunit beta Recombinant Rabbit mAb |
| 中文名称 | 磷脂酰肌醇激酶(PI3Kβ)重组兔单抗 |
| 英文别名 | PI3-kinase p110 subunit beta; p110 BETA; p110beta; PI3K beta; Phosphatidylinositol 3 kinase catalytic beta polypeptide; Phosphatidylinositol 4 5 bisphosphate 3 kinase 110 kDa catalytic subunit beta; Phosphatidylinositol 4 5 bisphosphate 3 kinase catalytic subunit beta isoform; Phosphatidylinositol-4; phosphoinositide 3 kinase catalytic beta polypeptide; PI3 kinase p110 subunit beta; PI3-kinase subunit beta; PI3K; PI3K beta; PI3K-beta; PI3Kbeta; PI3KCB; PIK3C1; Pik3cb; PK3CB_HUMAN; PtdIns 3 kinase p110; PtdIns-3-kinase subunit beta; PtdIns-3-kinase subunit p110-beta; 5-bisphosphate 3-kinase 110 kDa catalytic subunit beta; 5-bisphosphate 3-kinase catalytic subunit beta isoform. |
| 产品应用 | WB=1:500-2000, IHC-P=1:100-500, IHC-F=1:100-500, ICC/IF=1:50-200, IF=1:100-500 Not yet tested in other applications. |
| 交叉反应 | Human, Mouse, Rat |
| 抗体来源 | Rabbit |
| 免疫原 | A synthesized peptide derived from human PI3 kinase p110 beta |
| 亚型 | IgG |
| 性状 | Liquid |
| 纯化方法 | affinity purified by Protein A |
| 克隆类型 | Recombinant |
| 理论分子量 | 123 kDa |
| 浓度 | 1mg/ml |
| 储存液 | 0.01M TBS (pH7.4) with 1% BSA, 0.02% Proclin300 and 50% Glycerol. |
| 研究领域 | Cell Biology > Cell Cycle > Kinases/Phosphatases Immunology > Innate Immunity > TLR Signaling Signal Transduction > Protein Phosphorylation > Ser / Thr Kinases > Other Kinases Signal Transduction > Signaling Pathway > Lipid Signaling > Lipid Kinases |
| 亚基 | PIK3R2 or PIK3R3). Interaction with PIK3R2 is required for nuclear localization and nuclear export. Part of a complex with PIK3R1 and PTEN. Binding to PTEN may antagonize the lipid kinase activity under normal growth conditions. Part of a complex involved in autophagosome formation composed of PIK3C3 and PIK3R4. Interacts with BECN1, ATG14 and RAB5A. |
| 亚细胞定位 | Cytoplasm. Nucleus. Note=Interaction with PIK3R2 is required for nuclear localization and export. |
| 组织特异性 | Expressed ubiquitously. |
| 翻译后修饰 | Phosphorylation at Ser-1070 down-regulates lipid kinase activity. |
| 相似性 | Belongs to the PI3/PI4-kinase family. Contains 1 C2 PI3K-type domain. Contains 1 PI3K-ABD domain. Contains 1 PI3K-RBD domain. Contains 1 PI3K/PI4K domain. Contains 1 PIK helical domain. |
| 功能 | Phosphoinositide-3-kinase (PI3K) that phosphorylates PtdIns (Phosphatidylinositol), PtdIns4P (Phosphatidylinositol 4-phosphate) and PtdIns(4,5)P2 (Phosphatidylinositol 4,5-bisphosphate) to generate phosphatidylinositol 3,4,5-trisphosphate (PIP3). PIP3 plays a key role by recruiting PH domain-containing proteins to the membrane, including AKT1 and PDPK1, activating signaling cascades involved in cell growth, survival, proliferation, motility and morphology. Involved in the activation of AKT1 upon stimulation by G-protein coupled receptors (GPCRs) ligands such as CXCL12, sphingosine 1-phosphate, and lysophosphatidic acid. May also act downstream receptor tyrosine kinases. Required in different signaling pathways for stable platelet adhesion and aggregation. Plays a role in platelet activation signaling triggered by GPCRs, alpha-IIb/beta-3 integrins (ITGA2B/ ITGB3) and ITAM (immunoreceptor tyrosine-based activation motif)-bearing receptors such as GP6. Regulates the strength of adhesion of ITGA2B/ ITGB3 activated receptors necessary for the cellular transmission of contractile forces. Required for platelet aggregation induced by F2 (thrombin) and thromboxane A2 (TXA2). Has a role in cell survival. May have a role in cell migration. Involved in the early stage of autophagosome formation. Modulates the intracellular level of PtdIns3P (Phosphatidylinositol 3-phosphate) and activates PIK3C3 kinase activity. May act as a scaffold, independently of its lipid kinase activity to positively regulate autophagy. May have a role in insulin signaling as scaffolding protein in which the lipid kinase activity is not required. May have a kinase-independent function in regulating cell proliferation and in clathrin-mediated endocytosis. Mediator of oncogenic signal in cell lines lacking PTEN. The lipid kinase activity is necessary for its role in oncogenic transformation. Required for the growth of ERBB2 and RAS driven tumors. |
| 保存条件 | Shipped at 4℃. Store at -20℃ for one year. Avoid repeated freeze/thaw cycles. |
| 注意事项 | This product as supplied is intended for research use only, not for use in human, therapeutic or diagnostic applications. |
| 背景资料 | This gene encodes an isoform of the catalytic subunit of phosphoinositide 3-kinase (PI3K). These kinases are important in signaling pathways involving receptors on the outer membrane of eukaryotic cells and are named for their catalytic subunit. The encoded protein is the catalytic subunit for PI3Kbeta (PI3KB). PI3KB has been shown to be part of the activation pathway in neutrophils which have bound immune complexes at sites of injury or infection. Alternative splicing results in multiple transcript variants. [provided by RefSeq, Dec 2011]. |
| 应用 | 推荐稀释比例 |
| {WB} | {1:500-2000} |
| {IHC-P} | {1:100-500} |
| {IHC-F} | {1:100-500} |
| {ICC/IF} | {1:50-200} |
| {IF} | {1:100-500} |

风险提示:丁香通仅作为第三方平台,为商家信息发布提供平台空间。用户咨询产品时请注意保护个人信息及财产安全,合理判断,谨慎选购商品,商家和用户对交易行为负责。对于医疗器械类产品,请先查证核实企业经营资质和医疗器械产品注册证情况。
文献和实验tyrosine kinases (RTKs) and the concomitant assembly of receptor–PI3K complexes. These complexes localize at the membrane where the p110 subunit of PI3K catalyses the conversion of PtdIns(4,5)P2 (PIP2) to PtdIns(3,4,5)P3 (PIP3). PIP3 serves as a second
(IL-2 Receptor) alpha subunit primarily increases the affinity of ligand binding and is not known to contain a signaling domain, whereas the beta and gamma subunits participate in both ligand binding and signal transduction (Ref.1). The IL-2R signaling
Introduction of human 14-3-3 proteins
with several tyrosine-phosphorylated proteins and phosphatidylinositol 3-kinase (PI3-K)in T cells.We report here the identification of the 120-kDa 14-3-3tau-binding phosphoprotein present in activated T cell lysates as Cbl,a protooncogene product of unknown function
技术资料暂无技术资料 索取技术资料









